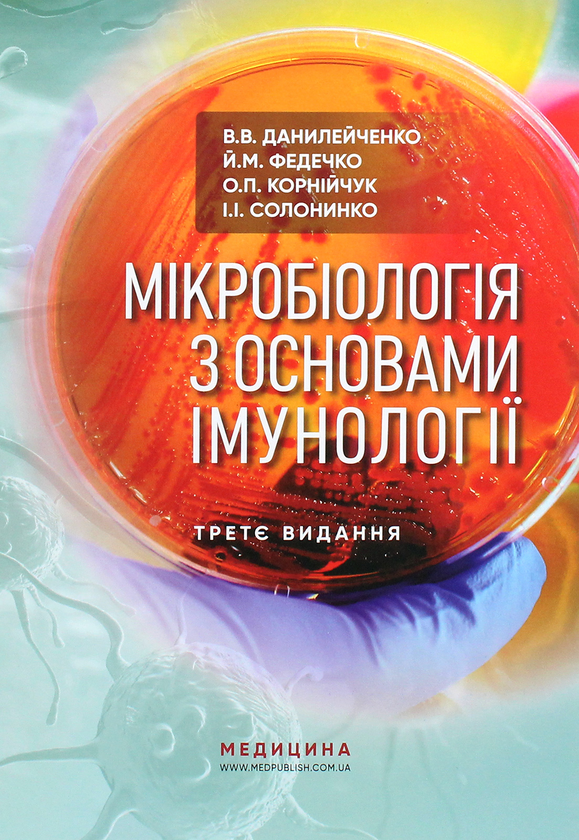

Практикум з медичної біології: навчальний посібник (ВНЗ І-ІІІ р. а.)
В наявностіНавчальна література
Зареєструйтесь або увійдіть, щоб додавати книги до списків
Зареєструйтесь або увійдіть, щоб вести читацький щоденник
Кількість сторінок296
Рік видання2017
Мова
Категорії
У навчальному посібнику вміщено перелік практичних занять з медичної біології, наведено методику їх проведення. У змісті кожного практичного заняття подано стислий теоретичний огляд основних питань, які розглядаються на занятті. Належну увагу приділено самостійній роботі та самоконтролю засвоєного програмного матеріалу.
Третє видання доповнено практичними заняттями з паразитології, зокрема темами: “Плоскі черви”, “Круглі черви”, “Членистоногі”, “Клас Павукоподібних”.
Для студентів вищих медичних навчальних закладів I-III рівнів акредитації та слухачів підготовчих курсів.
Де можна придбати
Книгарня Є
• Медицина
Немає в наявності 307 грн182.4 грн -4% При ввімкненому кешбеку від SenseBank

Коментарі
Немає коментарів. Будьте першим, хто залишить коментар!